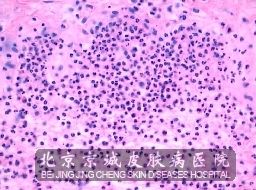

北京京城皮肤医院提供网络预约挂号服务
预约挂号热线:010-64888999
三级专科
医保定点
舒适环境
无假日
疱疹样皮炎的发病特点是什么?各位一定要对疱疹样皮炎的发病特点的问题进行详细的了解,才能够做到及时的就医,那么,到底疱疹样皮炎的发病特点是什么呢?下面就让我们北京京城皮肤医院皮肤病专家们,为您介绍一下疱疹样皮炎的发病特点吧,让各位能够对疱疹样皮炎的发病特点的问题有更深入的了解。
北京京城皮肤医院皮肤病专家根据个人多年的临床经验,研究总结出了对疱疹样皮炎的发病特点问题的答案,进行了下列内容的讲述,疱疹样皮炎是一种自身*性疾病,皮肤以发生红斑、丘疹、风团、水胞等多形性皮损为特征表现。
以上我们北京京城皮肤医院,为各位讲述的疱疹样皮炎的发病特点 ,希望对各位有所帮助,能够 的了解病情病因,才能 的将病情治疗,建议看一下自己的饮食习惯和生活习惯是否有问题,只有从上去改变生活质量,才能对疾病达到治疗的目的。010-64888999或010-64888999热线预约电话,可以与专家直接进行交流。
推荐阅读:
4.清洗空调预防皮炎